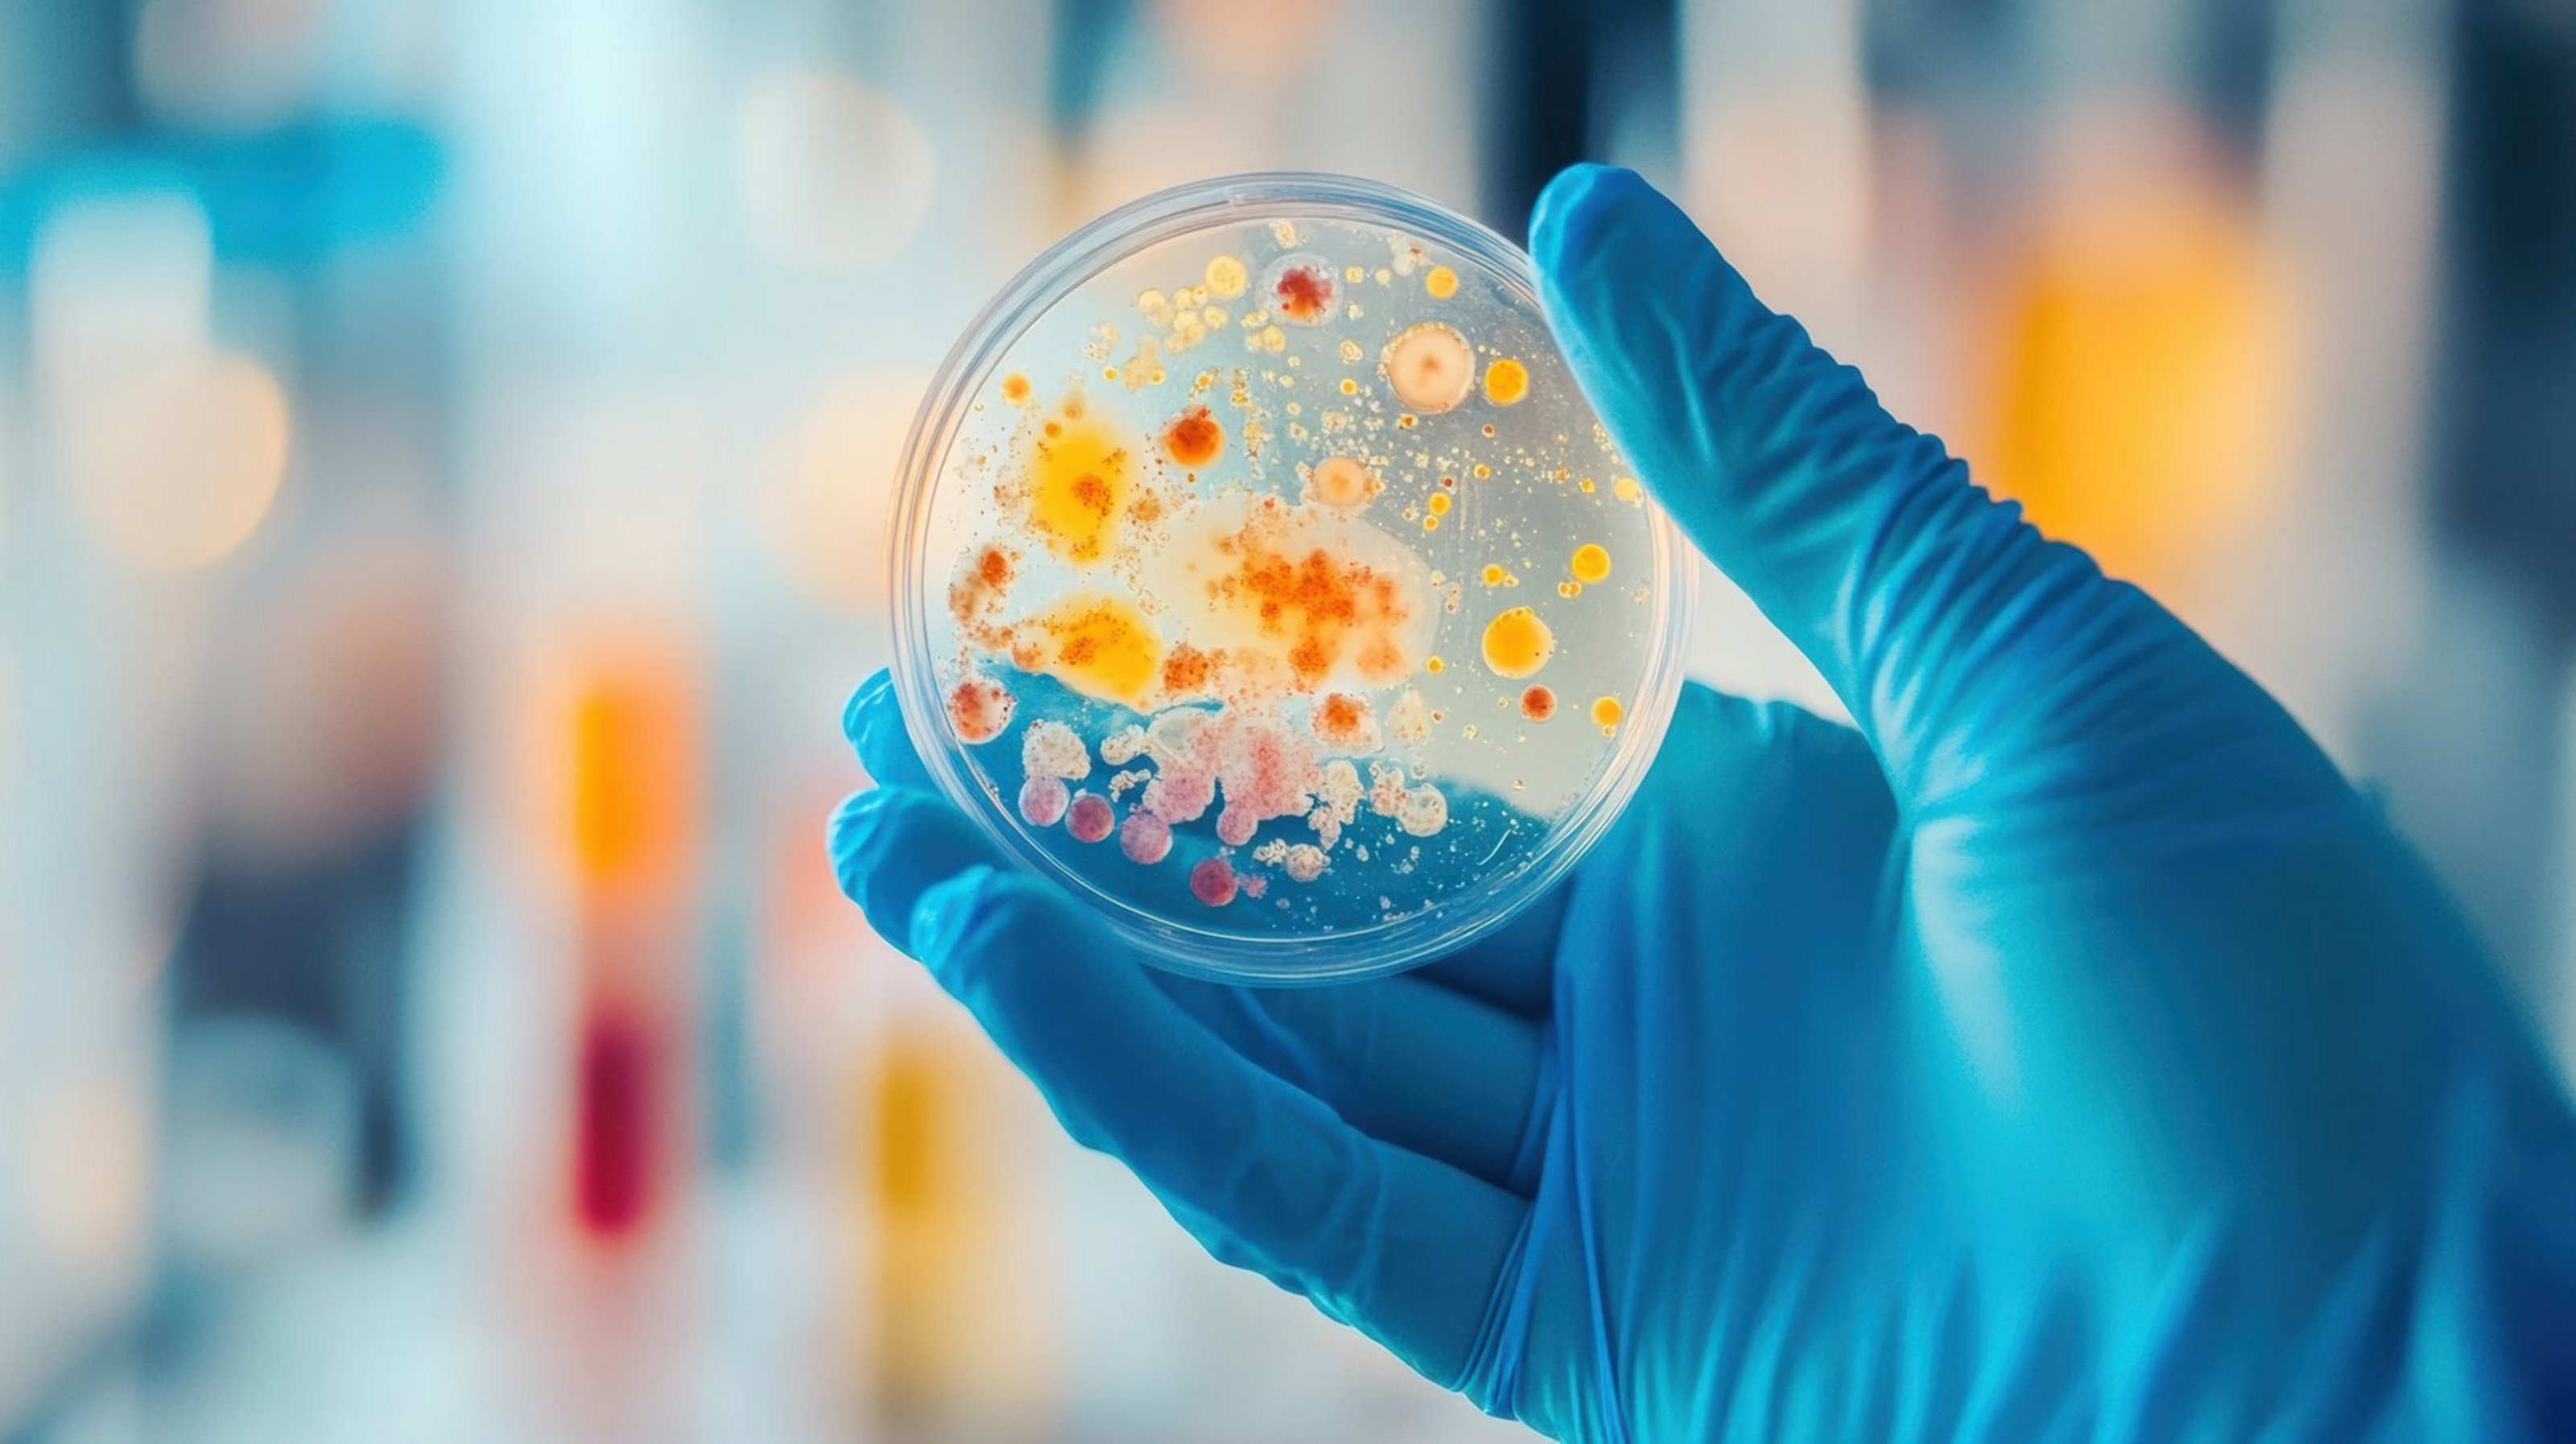

Deine Zukunft im Gesundheitsamt - mehr Vielfalt als Du denkst!
Der Öffentliche Gesundheitsdienst verbindet medizinische Expertise mit gesellschaftlicher Verantwortung. Ärztinnen und Ärzte im Gesundheitsamt arbeiten präventiv, bevölkerungsbezogen und interdisziplinär. Wir bieten engagierten Medizinstudierenden sowie Ärztinnen und Ärzten attraktive Möglichkeiten, den Öffentlichen Gesundheitsdienst kennenzulernen und aktiv mitzugestalten. Zudem profitierst du von planbaren Arbeitszeiten und modernen Arbeitsbedingungen, wie z.B. Homeoffice.
Lerne, wie Medizin, Gesellschaft und Politik zusammenwirken und entdecke neue Perspektiven für deine ärztliche Zukunft.
PJ im Gesundheitsamt
Der Kreis Coesfeld, die Stadt Münster und der Kreis Steinfurt planen, künftig PJ-Studierenden praxisnahe Einblicke in die vielfältigen Aufgaben des Gesundheitsamtes zu ermöglichen. Im Zuge dessen ist auch die Einführung des Praktischen Jahres vorgesehen. Erste Einblicke in das Angebot gab es bereits auf dem PJ-Day der Universität Münster am 17.4.2026.
Vier Fachdienste - viele Aufgaben
- Infektionsschutz / Umweltmedizin
-
- Ermittlung und Beratung im Zusammenhang mit verschiedenen Infektionskrankheiten, z. B. Tuberkulose, Windpocken, Masern
- Beratung und Diagnostik bezüglich sexuell übertragbarer Erkrankungen
- Begehung von Einrichtungen (Arztpraxen, Heilpraktiker, Kliniken etc.) nach Infektionsschutzgesetz
- Grundlagen zur Trink- und Badewasserüberwachung mit Begehung von Brunnen, Wasserwerken, Schwimmbädern o. Ä.
- Impfberatung
Hier geht es zu den einzelnen Gesundheitsämtern:
MÜNSTERLAND - DAS GUTE LEBEN!
Perspektiven für die ganze Familie
Das Münsterland bietet nicht nur attraktive Perspektiven im Öffentlichen Gesundheitsdienst, sondern auch für Partnerinnen und Partner vielfältige berufliche Chancen. Zahlreiche erfolgreiche mittelständische Unternehmen und “Hidden Champions” prägen die Region und schaffen ein starkes wirtschaftliches Umfeld.
So wird der Wechsel ins Münsterland für die ganze Familie zu einer langfristigen Perspektive.